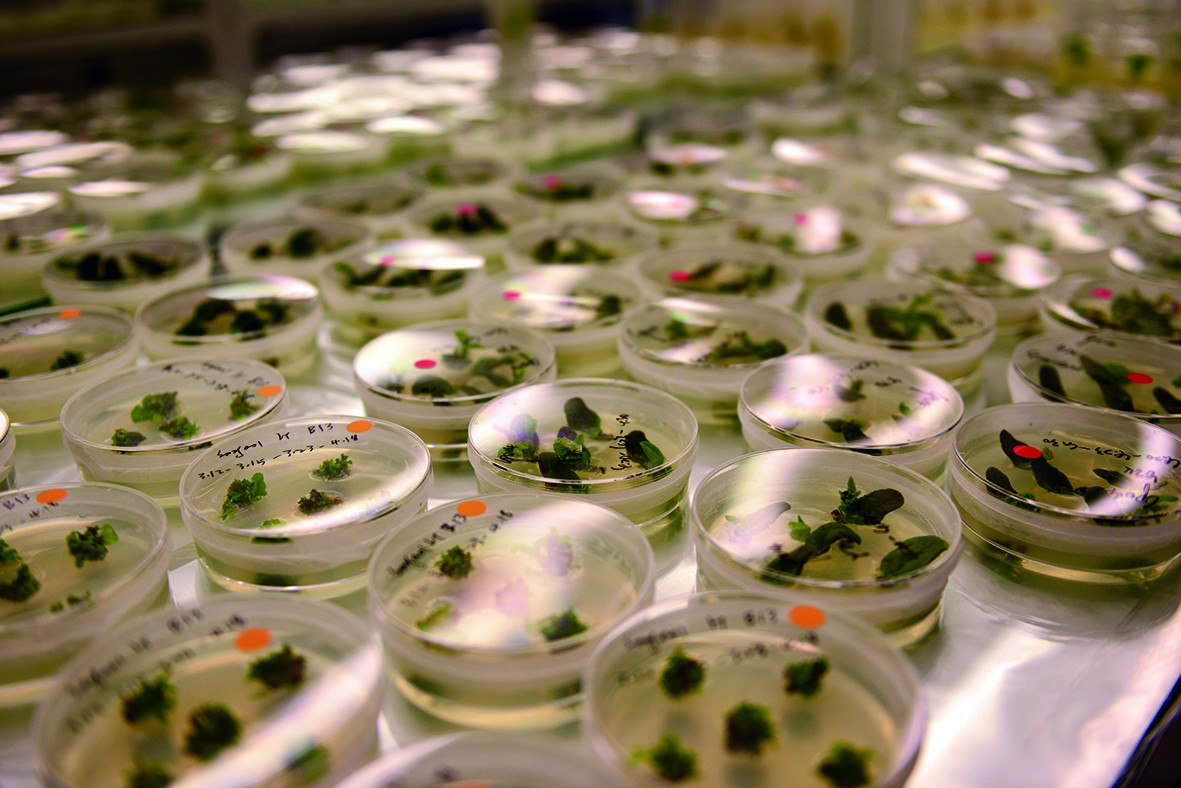

中國需要有自己的“種子基因字典”

本報赴三亞特派記者 趙覺珵 張鴻陪
在海南三亞崖州灣科技城,隆平生物技術(海南)有限公司是最早入駐的一批企業。作為全國最大種業公司隆平高科旗下子公司,隆平生物利用三亞的獨特氣候與自然環境優勢,重點研製生物育種的關鍵“芯片”技術:抗蟲新基因、規模化玉米/大豆轉化平台、玉米基因編輯技術等。隆平生物總經理呂玉平 近日在接受《環球時報》記者採訪時表示,經過多年的基礎育種技術等積累,國外種子公司已形成一本“字典”,能根據“字典”培育出更多更優秀的新品種,而中國企業目前還沒有這樣的“字典”。這需要國家的支持、科研機構和企業的持續投入,才有望在未來10至20年中徹底實現中國糧食自主。
*環球時報:*一些人説,我國是種子資源大國,但還不是強國,目前我國種子資源是什麼樣的狀況?
*呂玉平:*我國種子資源的豐富程度及其質量要取決於具體物種。水稻主要起源於中國,我國的水稻種子資源是非常豐富的,包括常規水稻(栽培水稻)和野生水稻在內,我國的種子資源毫無疑問是全球第一,不僅豐富,也是種子資源和育種技術的強國。早在1970年,袁隆平團隊就發現了水稻“野敗”(野生的雄性敗育稻,“野敗”的發現為水稻雄性不育系的選育、三系雜交水稻的研究成功打開突破口——編者注)。近50年來,成千上萬的中國科學家在這一領域不斷深耕,可以説中國在水稻育種方面牢牢佔據世界第一的位置。
與水稻不同的是,大豆雖然也起源於中國,我國的大豆種子資源也很豐富,但這些種子資源很多都流失到國外。儘管在過去40多年中,我國在大豆育種上有投入有產出,但投入和產出都和國外有較大差距,特別是在大豆抗病性狀等方面的研究。經過二三十年的研究,美國在大豆育種方面異軍突起。
最初中國是大豆出口國,但從上世紀90年代開始進口大豆。2020年中國大豆進口超過1億噸。我曾經初步計算過,如果中國不進口大豆,僅靠本土供給,至少需要9億畝地。這是什麼概念?我國所有糧食作物的耕地面積只有18億畝,因此用9億畝地來種大豆是不可能的。
第三種情況是玉米,它起源於美洲,是目前全球第一大的糧食作物或飼料作物,而我國的玉米種子資源既不豐富,也不是強國。2020年,我國進口玉米上千萬噸。
*環球時報:*糧食安全問題正受到越來越多的重視,“卡脖子”的擔憂也被頻繁提起。您認為我國糧食安全“卡脖子”主要集中在哪些作物上,與國際上主要的差距在哪?
*呂玉平:*當我們提到中國糧食安全“卡脖子”的問題,要首先分析卡在哪,主要是去年我國進口量最大的兩款農產品——大豆和玉米。從表面上看,國外玉米和中國玉米沒什麼區別,但如果深入分析會發現,國外進口玉米和大豆種子都是轉基因的,而國內種子都是非轉基因的。我國需要進口大量大豆和玉米,很大程度是因為我國單位土地產量只有國外的40%到60%。這之間的差距是轉基因導致的。
目前看,國外玉米和大豆種子主要的轉基因性狀是抗蟲和抗除草劑。以大豆為例,大豆本身只長到80釐米或1米高,但有的雜草可以長到1.5米,除草是必須的。國際上大的種子公司的大豆有抗除草劑的轉基因性狀,噴灑除草劑後會選擇性殺死雜草,不會影響大豆,而我國大豆還需要人工除草,或用昂貴的除草劑。
對玉米而言,無論在哪個國家,玉米種植過程中都要經受數十種害蟲危害,在蟲害嚴重的年份,不打藥幾乎顆粒無收。從國外進口的玉米種子含有抗蟲的轉基因,可免受害蟲危害,與抗除草劑的轉基因加在一起,能幫助玉米大豆增產或保產15%-30%。
*環球時報:*我國與美國等國家在育種方面的差距是怎麼形成的?
*呂玉平:*差距一方面源於國外公司在轉基因領域的系統性投入,另一方面也源於基礎育種技術的積累。以全球最大的種子公司之一的孟山都為例,其研發人員超過5000人,每年研發投入就接近100億元人民幣,中國還沒有一家企業能做到這樣程度的投入。隆平高科已經是中國第一的種業公司,但整體研發投入也只有4億元人民幣左右。
具體來講,國外種子公司已形成一本“字典”,它對外不公開不發表,也不申請專利,但作用巨大。以玉米為例,比如其基因中有上千個位點影響增產或是減產,假設某種玉米中有上百個位點是有益的,上百個不利的,依據“字典”就可以得知具體位點的好壞,在育種過程中去蕪存菁,有助於培育出具備更多有益位點、更少不利位點的新品種。
但中國企業目前還沒有這樣的“字典”,還不清楚這些具體位點的作用。相比之下,國外企業與科研機構在這方面的研究已持續三四十年甚至更長,但我國投入還是比較少的。這很大程度上因為這種研究的投入產出比很低,即使找出某個位點的作用,但對於成千上萬的位點而言,一個位點不足以令產量明顯提高。這是一項龐大的系統性工作,我國要真正地解決種業翻身仗,解決玉米和大豆“卡脖子”問題,育種技術一定要上去,我們也希望國家加大投入。如果科研機構和一批種業公司一起努力10至20年,我們是可以解決這一問題的。反過來,打好種業翻身仗的難度是很大的。▲